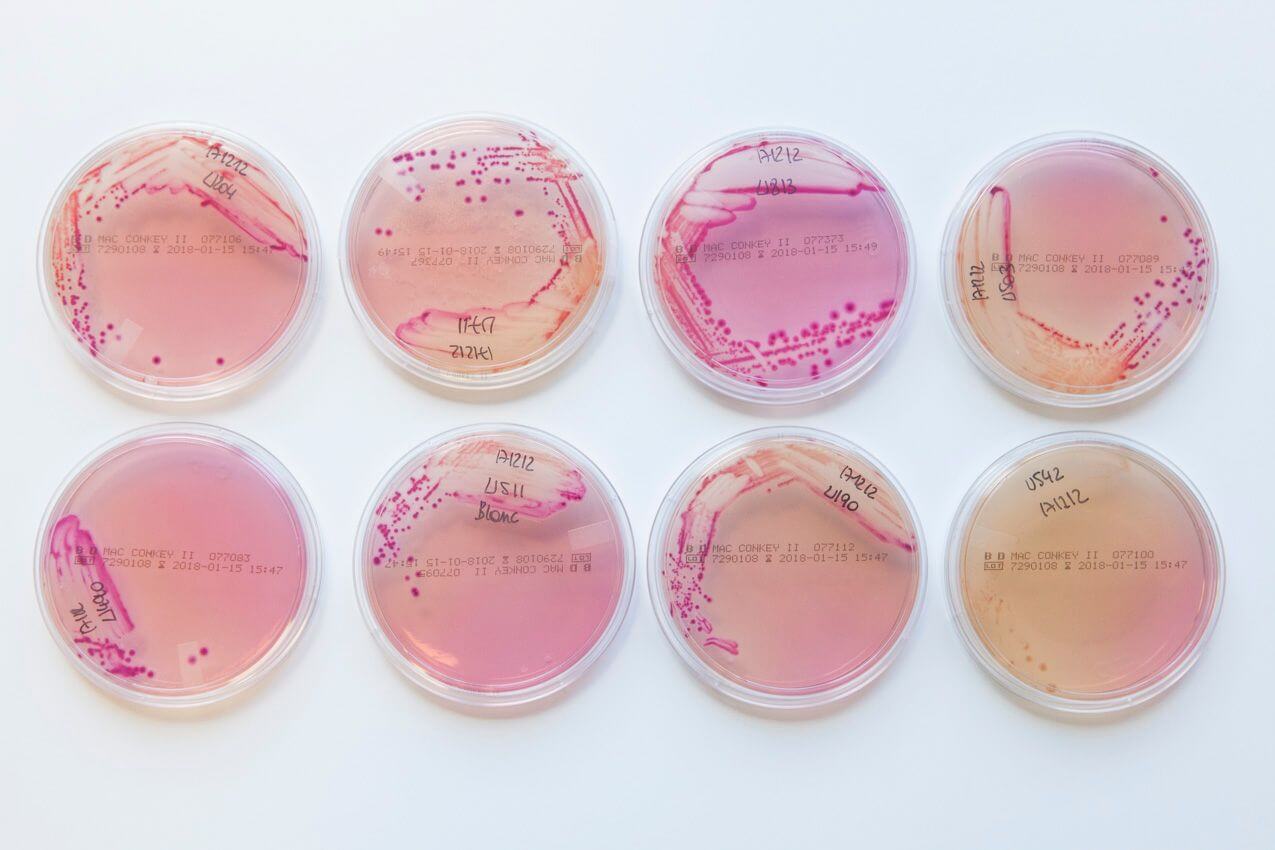

ITM and COVID-19
In 2021 globally, more than three million people died of COVID-19 - the novel coronavirus disease. Our scientists have been fully committed to limiting the impact of the disease and have joined forces with experts in Belgium and abroad to map the epidemic, find treatments through biomedical research and clinical trials and study its impact on people and society. ITM is a part of BelCoVac - a consortium of nine Belgian research, public health and higher education institutions. This initiative brought together several non-commercial clinical trials and follow-up projects in the context of COVID-19 vaccines marketed in Belgium. Thanks to their work, research on COVID-19 vaccines is conducted, recorded and reported in a uniform way. The ITM virology lab was instrumental in providing the virus-neutralising antibody results in our high-security laboratories.

ITM prepares for final phase in fight against sleeping sickness
Human African trypanosomiasis (HAT) or sleeping sickness is a disease caused by the Trypanosoma parasite, which is transmittable by the tsetse fly. The disease is fatal when left untreated. ITM has taken a major role in the fight against sleeping sickness for decades and has a long tradition in developing and manufacturing diagnostic tests, which are now used in all HAT control programs.

The search for exotic mosquitoes in Belgium continues
Exotic mosquitoes are spreading as a result of increased globalisation and climate change. An example is the tiger mosquito or Aedes albopictus, which can carry pathogens such as dengue, chikungunya and Zika virus. This species was able to establish itself in Southern Europe and has also been spotted in Belgium. Early detection enables better control.

Journal highlight
Challenges in interpreting SARS-CoV-2 serological results in African countries

Preventing type 2 diabetes among women in the DRC
Noncommunicable diseases (NCDs) such as diabetes, cardiovascular diseases, respiratory diseases, cancer and others kill 41 million people annually, and 77% of these deaths occur in low- and middle-income countries. In a new project called Kis-Santé, ITM researchers aim to develop and implement a programme for the prevention of type 2 diabetes and gestational diabetes among women in Kisantu, DRC, through the promotion of a healthy lifestyle and the maintenance of a healthy weight. The programme will also be evaluated through a cluster-randomised clinical trial in six primary healthcare facilities in Kisantu, where 300 participants will be recruited. Researchers are partnering with Memisa-DRC for the operational activities, the local health systems, and the DRC’s Ministry of Health for outreach and potential scaling up. The project is sponsored by the City of Antwerp.

Towards a new state-of-the-art, versatile and safe blood self-sampling device
Home-based self-tests for infectious diseases are on the rise. Currently, even WHO recommends integrating self-tests and home-based self-sampling into health care for the control of HIV and STIs (sexually transmitted infections). Nowadays, a microcontainer and the free-fall method are still used to collect whole blood at home for the detection of HIV and syphilis. This is very unhygienic, uncomfortable and often collects an insufficient amount of blood to carry out all the necessary tests. ITM researchers are developing a new device that circumvents these shortcomings. The new device would still use the finger stick method but will integrate it with a collection tube, sparing patients from having to put the blood into the tube themselves. This method would be more hygienic and could double the amount of blood collected. Researchers aim to facilitate the diagnostic process and to make the device available in lower-resource settings as a cheaper diagnostic alternative. For its development, ITM is collaborating with Voxdale. Financial support comes from the Flemish Agency for Innovation and Entrepreneurship (VLAIO).

Journal highlight
The Burden of Malnutrition and Fatal COVID-19: A Global Burden of Disease Analysis

Journal highlight
A double-edged sword-telemedicine for maternal care during COVID-19: findings from a global mixed-methods study of healthcare providers

New basic research projects to underpin new innovations for Leishmania elimination
Leishmaniasis is a neglected tropical disease, spread by sandfly bites. Its most common form in people is cutaneous leishmaniasis, which causes painful skin sores, and visceral leishmaniasis, which affects internal organs and is lethal if left untreated. Visceral leishmaniasis is the second-largest parasitic killer in the world after malaria, responsible for 30,000 deaths each year.

Journal highlight
High throughput single-cell genome sequencing gives insights into the generation and evolution of mosaic aneuploidy in Leishmania donovani

Journal highlight
Trypanosoma brucei gambiense-iELISA: A Promising New Test for the Post-Elimination Monitoring of Human African Trypanosomiasis

Community pharmacies can play a large role in combatting AMR
Antimicrobial resistance (AMR) is a major threat to public health worldwide. Particularly in low-income countries that have high rates of infectious diseases and where people often receive antibiotics without prescription from local pharmacies. The CABU-EICO project, coordinated by ITM, aims to improve antibiotic use and hygiene practices, to ultimately reduce antimicrobial resistance. Starting from 2022, the research team will develop and evaluate a one-year behavioural intervention for communities and community pharmacy staff in Burkina Faso and the DRC. The project, one of the new JPIAMR 13th transnational call projects, receives financial support from FWO, the Medical Research Council in the UK, ANRS | Emerging Infectious Diseases in France and the Swedish International Development Cooperation Agency. The consortium includes Institut de Recherche en Science de la Santé (Burkina Faso), Institut Médical Evangélique de Kimpese (DRC), University of Antwerp (Belgium), Institut Pasteur (France), University of Cambridge (UK) and University of Oxford (UK).

Journal highlight
An alarming high prevalence of resistance-associated mutations to macrolides and fluoroquinolones in Mycoplasma genitalium in Belgium: results from samples collected between 2015 and 2018

Journal highlight
Deep amplicon sequencing for culture-free prediction of susceptibility or resistance to 13 anti-tuberculous drugs

FWO awards funding for ITM’s collaborative research
The Research Foundation of Flanders (FWO) has awarded five PhD projects, five collaborative research projects and one scientific network to ITM in 2021. The research topics, aligning with ITM’s research priorities, include modelling of pathogen spread and field research on pathogen spill-over to human populations; antimicrobial resistance in tuberculosis (TB) and malaria; and new strategies to accelerate elimination of leishmaniasis and onchocerciasis.

40 years HIV research at ITM - from the AIDS epidemic to sustainable HIV infection care and research innovation
The importance of ITM in HIV and AIDS research cannot be overestimated. It is thanks to ITM that this disease was recognised as an African heterosexual disease which affects poor people. ITM has also been a medical services provider and a taboo-breaking champion of HIV-infected people in Belgium for decades. The institute has a strong commitment to HIV/AIDS research in the areas of virology, epidemiology, prevention, education, diagnosis, therapy and social issues.

Research inspiring solutions in the fight against antimicrobial resistance
Antimicrobial resistance (AMR) is an urgent global health threat that develops when bacteria, viruses, fungi and parasites change over time and no longer respond to treatment. Globalisation, migration and (medical) tourism will inevitably lead to the world-wide spread of new (multi-)resistant mutant pathogens.

A clinical research platform for virus detection in tropical fever patient populations
Important patient sample collections have been gathered over recent years through collaborative ITM research projects on acute undifferentiated febrile illness with partner institutions in the South (sub-Saharan Africa, Asia and Latin America) and clinical studies in the ITM travel clinic. Interestingly, targeted diagnostic tools (e.g. rapid tests, serology and PCR) have failed to identify underlying causative agents of febrile illness in most patient samples.Within the framework of the new METATROPICS project financed by EWI, ITM aims to build a platform that uncovers and describes endemically circulating viral pathogens and potentially also new viruses causing febrile illnesses. The research will be carried out by sequencing all nucleic acid sequences in a patient sample. Beyond available samples, this platform will form the basis for future prospective epidemiologic viral outbreak surveillance to be rolled out locally in tropical settings and combining human, vector and animal reservoir sampling.

Journal highlight
Evaluating SARS-CoV-2 spike and nucleocapsid proteins as targets for antibody detection in severe and mild COVID-19 cases using a Luminex bead-based assay.

A promising new tool for tuberculosis testing
The Lung Flute®, a flute-shaped hand-held device that helps reduce thin mucus, is a promising tool to increase the volume and quality of tuberculosis testing. ITM researchers are testing a simple and inexpensive paper version of the Lung Flute®, the Lung Flute ECO®, to enable sputum sample collection for tuberculosis testing. Initial testing showed similar performance of the Lung Flute ECO® at lower cost and reduced environmental impact. Researchers will evaluate its performance in target groups in Cameroon to determine its potential contribution to the volume of molecular testing, diagnostic yield, as well as safety, acceptability, and cost-effectiveness. If viable, the Lung Flute ECO® will be an affordable and eco-friendly tool for the early detection of tuberculosis.
The study is funded by the Global Health Innovation Technology Fund. The partners for the study are the Research Institute of Tuberculosis (Japan), the Center for Health Promotion and Research (Cameroon), and Acoustic Innovations (US).

Ensuring the continuity of care for women and newborns during disruptive unforeseen events
The COVID-19 pandemic shook health systems worldwide, including the care for pregnant women and newborns. To understand the impact of the pandemic on the provision of essential maternal and newborn care globally, ITM launched a global study - a collaboration of two European and seven African institutions. One of the sub-studies was carried out in 2020-2021, and it prospectively assessed how maternal healthcare was provided in six referral hospitals in Guinea, Nigeria, Tanzania and Uganda during the first year of the COVID-19 pandemic. These hospitals are located in crowded urban areas, which were often epicentres of the pandemic. This study also serves as a platform for the exchange of information and experiences across the contexts studied. Furthermore, this research contributes to more people-centred, integrated, accountable, equitable and resilient health systems that lead to responsive and high-quality care for all mothers and newborns. This study was made possible by ITM’s COVID-19 Pump Priming Fund supported by EWI and by the Embassy of the United Kingdom in Belgium.

An interdisciplinary take on malaria
Malaria is a tropical disease spread by mosquitoes (as vectors) that still kills more than half a million people every year.
ITM is part of the interdisciplinary CEASE project, led by the Liverpool School of Tropical Medicine (LSTM), which aspires to map the spread of the malaria mosquito vector Anopheles stephensi in Ethiopia and Sudan. The social science work package, led by ITM researchers, aims to understand how social and ecological factors affect the spread of the mosquito in this region. They will also model the public health impact and the cost-effectiveness of different emerging vector control strategies. Besides LSTM and ITM, the collaboration brings together experts from the Jimma University and Armauer Hansen Research Institute (Ethiopia), the University of Khartoum (Sudan), Imperial College London and Lancaster University (UK). The project is funded by the Wellcome Trust.

Improving leprosy prevention strategies in the Comoros
Since 2018, ITM researchers have been conducting research into leprosy, an ancient infectious disease transmitted by Mycobacterium leprae. Although it is assumed that humans transmit the disease to other humans, it is still poorly understood exactly how this happens.
ITM is currently involved in an ongoing cluster randomised trial in the Comoros (PEOPLE study). Here the study team is producing spatial-epidemiology data and phylogenetic trees - diagrams representing evolutionary relationships between organisms. The institute has now also started a follow-up study called SNA Leprosy, financed by EWI. This is to compliment the data emerging from the PEOPLE study with the analysis of social networks. Here, they will study entire villages combining qualitative and quantitative research methods. By understanding how transmission occurs, researchers will know who benefits most from leprosy screening within the patient's social network - beyond those living nearest. They will be able to formulate concrete recommendations to improve leprosy prevention and control efforts in the Comoros, and more generalisable recommendations that could benefit leprosy interventions globally. For this study ITM is teaming up with the Damien Foundation.
Innovate and evaluate to detect antimicrobial resistance in tuberculosis
Accurate and timely detection of antimicrobial resistance (AMR) is key to patient management. Rifampicin is one of the key anti-tuberculosis (TB) drugs, but current routine diagnostics fail to detect a small percentage of rifampicin-resistant TB strains. Consequently, patients are not adequately treated, have low chances of being cured and are likely to continue transmitting the disease. In a collaborative study, ITM researchers applied a non-commercial method, Thin Layer Agar (TLA), to detected rifampicin-resistant strains. TLA, which was previously extensively evaluated at ITM, is an affordable method that provides accurate test results, detecting also resistant strains missed by the other methods. Importantly, clinical samples require very limited manipulation, eliminating the need for high-level biohazard containment. The TLA method is now under evaluation for its performance on the detection of bedaquiline resistance. Bedaquiline is a novel antibiotic, used in the treatment of multidrug-resistant TB, that significantly shortens the treatment duration.
Ardizzoni et al. 2021 Antimicrobe Agents Chemother

Using cutting edge gene sequencing technologies in the fight against drug-resistant malaria
Malaria is a mosquito-borne infectious disease caused by single-celled microorganisms of the Plasmodium group. Of the five species infecting humans, P. vivax is the predominant species outside of Africa, causing millions of cases. A major challenge to achieve malaria elimination by 2030 is the parasite’s resistance against chloroquine. While the first cases of P. vivax chloroquine resistance (PvCQR) were reported in 1989, the markers and mechanism of chloroquine resistance (CQR) remain unknown, hampering molecular surveillance and accurate diagnosis.
In order to address PvCQR, ITM researchers will capitalise on a large collection of existing P. vivax clinical samples to pioneer in the application of cutting-edge RNA sequencing technologies. They will unravel the network of genes underlying PvCQR, and the impact of parasite stage and infection complexity in treatment outcome. The results of the study will directly benefit P. vivax patients and drug resistance surveillance, while advancing research with new protocols, tools, datasets and transgenic lines to investigate P. vivax biology.
Partner institutions for the study include the Royal Veterinary College (UK), the National Institute of Malariology, Parasitology and Entomology (Vietnam), the Institute of Medical Research (Papua New Guinea) and the Universidad Peruana Cayetano Heredia (Peru).
Seed funding inspires three new cross-organisational research projects
In the framework of the second edition of the Joint Pump Priming Programme (JPPP), ITM researchers submitted joint applications with outside researchers who are willing to co-invest in the development of a new research idea. Three joint projects were awarded in 2021 and include two collaborations with the University of Antwerp, one on health governance in challenging urban environments and one on Leishmania parasites. For the third project, ITM is teaming up with the Department of Microbiology, Immunology and Parasitology at the Universidade Federal de São Paulo to study epigenetic regulation of P. knowlesi (malaria-causing parasite) phenotypes.
































